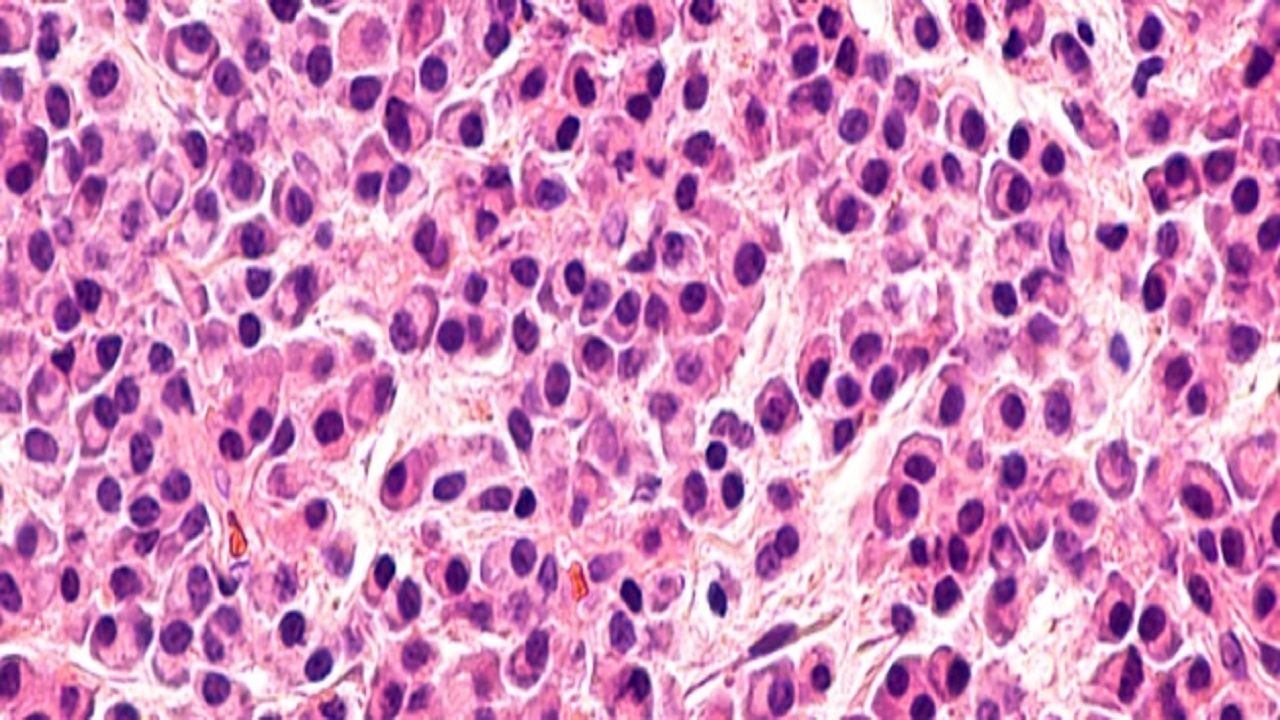

نحوه درمان خونریزیهایی که بند نمیآیند
ترومبوسیتوپنی زمانی رخ میدهد که تعداد پلاکتها در خون کاهش یابد و فرد خونریزی بیش از حد داشته باشد.
به گزارش سایت طلا -افراد مبتلا به ترومبوسیتوپنی پلاکت پایینی دارند. پلاکتها به لخته شدن خون (قطع خونریزی) کمک میکنند. هنگامی که تعداد پلاکت شما کم است، ممکن است کبودی و خونریزی بیش از حد داشته باشید. در این گزارش ما یاد میگیریم "چگونه ترومبوسیتوپنی را درمان کنیم. "
انواع و درمانهای مخصوص سرطان و بیماریهای خودایمنی میتواند باعث این وضعیت شود. سطح پلاکت اغلب زمانی بهبود مییابد که علت زمینهای برطرف شود.
ترومبوسیتوپنی چیست؟
ترومبوسیتوپنی زمانی رخ میدهد که تعداد پلاکتها در خون کاهش یابد. به پلاکتها لخته خون نیز میگویند. این نوع سلولهای خونی به هم میچسبند تا لختههای خونی را تشکیل دهند که به توقف خونریزی کمک میکند.
مغز استخوان بافت نرم و اسفنجی شکلی است که درون استخوانها همه سلولهای خونی از جمله پلاکتها از آن ساخته شدهاند. افراد مبتلا به ترومبوسیتوپنی پلاکت کافی برای تشکیل لخته خون ندارند. اگر زخم یا آسیب دیگری دارید، ممکن است خونریزی شدید داشته باشید و متوقف کردن خونریزی ممکن است دشوار باشد.
چه کسانی ممکن است به ترومبوسیتوپنی مبتلا شوند؟
ترومبوسیتوپنی میتواند افراد در هر سن و جنس را تحت تاثیر قرار دهد. به دلایل ناشناخته، حدود ۵ درصد از زنان باردار درست قبل از زایمان ترومبوسیتوپنی خفیف دارند.
سه دسته اصلی ترومبوسیتوپنی:
تخریب پلاکتهای شبیه به وجود اتوآنتی بادیهای متصل به سطح پلاکتها است.
ترومبوسیتوپنی، مانند فردی است که طحال یا بیماری کبدی بزرگ دارد.
کاهش تولید پلاکت، همانطور که در برخی از بیماریهای مغز استخوان رخ میدهد.
دلایل ترومبوسیتوپنی
در موارد نادر، ترومبوسیتوپنی ارثی است یا از پدر به فرزند منتقل میشود. معمولاً تعداد کم پلاکتها به دلیل برخی اختلالات، شرایط و داروها ایجاد میشود. این شامل:
بیماریهای خود ایمنی که باعث ITP میشوند. مثل لوپوس
بیماریهای مغز استخوان، از جمله کم خونی آپلاستیک، لوسمی و برخی از لنفوم ها.
درمانهای سرطان مانند شیمی درمانی و رادیوتراپی.
بزرگ شدن طحال به دلیل سیروز یا بیماری گوچر. طحال بزرگ شده پلاکتها و سایر سلولهای خونی را به دام میاندازد و از گردش آنها در خون جلوگیری میکند.
قرار گرفتن در معرض مواد شیمیایی سمی از جمله آرسنیک، بنزن و آفت کش ها.
داروهایی برای درمان عفونتهای باکتریایی (آنتی بیوتیک ها)، تشنج (صرع)، مشکلات قلبی یا هپارین ضد انعقاد.
ویروسهایی مانند هپاتیت C، CMV، EBV و HIV.
علائم کاهش پلاکت چیست؟
تعداد پلاکت کم
برخی از افراد مبتلا به ترومبوسیتوپنی خفیف هیچ علامتی ندارند. اغلب یکی از اولین علائم خونریزی بینی است که متوقف نمیشود.
سایر علائم کاهش تعداد پلاکت عبارتند از:
خونریزی لثه
وجود خون در مدفوع (سیاه، قیری)، ادرار (هماچوری) یا استفراغ.
قاعدگی سنگین
کک و مک (نقاط کوچک قرمز یا بنفش روی پاها که شبیه بثورات پوستی هستند).
پورپورا (کبودی بنفش، قرمز یا قهوه ای) یا کبودی خفیف.
خونریزی از رکتوم.
تشخیص و آزمایشات
اگر در کنترل خونریزی یا سایر علائم ترومبوسیتوپنی مشکل دارید، پزشک ممکن است موارد زیر را انجام دهد:
معاینه فیزیکی: ارائه دهنده مراقبتهای بهداشتی شما سابقه خانوادگی و پزشکی شما را بررسی میکند. در مورد داروهایی که مصرف میکنید صحبت خواهید کرد. پزشک همچنین کبودی، بثورات پوستی (پتشی) و بزرگ شدن طحال یا کبد را بررسی میکند.
آزمایش خون: شمارش کامل خون (CBC) سطح پلاکت ها، گلبولهای سفید و گلبولهای قرمز را بررسی میکند.
آزمایش انعقاد: آزمایش انعقاد زمان لخته شدن خون را اندازه گیری میکند. این آزمایشها شامل زمان ترومبوپلاستین جزئی (PTT) و زمان پروترومبین (PT) میباشد.
اگر تعداد پلاکت پایینی دارید، پزشک ممکن است آزمایشهای دیگری را برای یافتن علت تجویز کند، مانند:
بیوپسی مغز استخوان: نمونه برداری از مغز استخوان میتواند به تشخیص بیماری یا سرطان مغز استخوان کمک کند.
مطالعات تصویربرداری: سونوگرافی یا سی تی اسکن ممکن است طحال بزرگ، غدد لنفاوی بزرگ یا سیروز را نشان دهد.
مدیریت و درمان
اگر تعداد پلاکت پایین شما باعث مشکلات جدی نشود، ممکن است نیازی به درمان نداشته باشید. اغلب اوقات ارائه دهندگان مراقبتهای بهداشتی میتوانند تعداد پلاکتها را با درمان علت زمینهای بهبود بخشند. این رویکرد ممکن است شامل تغییر داروها باشد.
درمانهای دیگر عبارتند از:
انتقال خون برای افزایش موقت سطح پلاکت: تزریق پلاکت تنها در صورتی انجام میشود که تعداد پلاکتها بسیار کم باشد.
اسپلنکتومی: استروئیدها (پردنیزولون یا دگزامتازون)، ایمونوگلوبولینها (پروتئینهای آنتی بادی) و سایر داروها تخریب پلاکتها را کاهش داده و تولید پلاکت را تحریک میکنند.
عوارض ترومبوسیتوپنی
افراد مبتلا به ترومبوسیتوپنی شدید در معرض خطر از دست دادن خون یا خونریزی داخلی و خارجی هستند. خونریزی داخلی در سیستم گوارش یا مغز (خونریزی داخل جمجمه ای) میتواند تهدید کننده زندگی باشد.
برداشتن طحال خطر عفونت را افزایش میدهد. طحال بخشی از سیستم ایمنی بدن شماست. این به بدن شما کمک میکند تا با میکروبها مبارزه کند. به همین دلیل، واکسنهای زیادی به بیمارانی داده میشود که برای جلوگیری از عفونت باید طحال خود را خارج کنند.